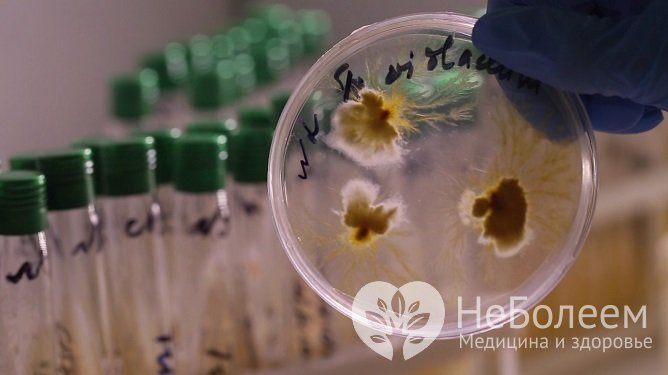
Обязательным этапом лечения арахноэнтомозов является исследование паразитов на инфекции

Воспользуйтесь поиском по сайту:
Арахноэнтомозы
Содержание статьи:
Арахноэнтомозы – большая группа разнородных паразитарных заболеваний, вызываемых перепончатокрылыми насекомыми и паукообразными клещами. Эти заболевания широко распространены среди животных, люди страдают ими значительно реже.
 Арахноэнтомозы вызываются паукообразными клещами и перепончатокрылыми насекомыми
Арахноэнтомозы вызываются паукообразными клещами и перепончатокрылыми насекомымиПричины и факторы риска
Источник заражения человека арахноэнтомозами – внешняя среда. Несоблюдение мер личной гигиены является предрасполагающим фактором к развитию заболеваний данной группы у людей.
Формы заболевания
Арахноэнтомозы делятся на три большие группы:
- Поверхностные. Они вызываются временными (блохами, комарами) или постоянными (чесоточными клещами, вшами) эктопаразитами кожи.
- Глубокие. Возбудители – членистоногие, паразитирующие во внутренних тканях и органах человека (лингватулиды, эндопаразитические клещи, личинки жуков и мух).
- Токсико-аллергические. Возникают в результате аллергической или токсической реакции на укусы членистоногих (например, скорпионов).
В зависимости от возбудителя арахноэнтомозы бывают следующих видов:
- лингватулидозы (вызываются ракообразными);
- акариазы и арахнозы (вызываются паукообразными);
- мириаподиазы (вызываются многоножками);
- энтомозы (вызываются насекомыми).
Диагностика поверхностных арахноэнтомозов, таких как комариная аллергия, педикулез, чесотка, демодекоз, обычно не вызывает затруднений. В случае глубоких форм заболевания могут возникать диагностические сложности.
Симптомы
Ввиду огромного разнообразия паразитов, которые становятся причиной развития арахноэнтомозов, клиническая картина каждой группы имеет свои особенности.
Лингватулидозы
Эта группа арахноэнтомозов вызывается паразитирующими ракообразными, которые в силу своего образа жизни утратили определенные признаки, присущие членистоногим.
Ракообразные семейства лингватулидов способны вызывать у человека пороцефалез, лингватулез, армиллифериоз. Их признаки:
- фарингит;
- отек голосовых связок;
- лимфадениты;
- аллергизация организма;
- пневмония;
- поражение печени с развитием желтухи;
- непроходимость кишечника.
 Фарингит и лимфаденит могут быть симптомами арахноэнтомоза
Фарингит и лимфаденит могут быть симптомами арахноэнтомозаМириаподиазы
Мириаподиазы – это группа арахноэнтомозов, вызываемых паразитированием многоножек.
Многоножки попадают в полость носа, придаточных пазух или рта во время сна человека на открытом воздухе либо во время приема пищи. Инвазия доставляет больному серьезные страдания. Для нее характерны:
- острое воспаление слизистой оболочки в месте поражения;
- кровотечение;
- невыносимый зуд;
- обильное истечение слизи;
- чувство жжения;
- сильная боль;
- тяжелые нервные расстройства;
- судорожные припадки.
Многоножки выходят наружу при кровотечении или удаляются ЛОР-врачом, после чего симптоматика быстро стихает.
Наиболее частые осложнения арахноэнтомозов – гнойно-воспалительные заболевания кожи и системные аллергические реакции.
Вместе с овощами и фруктами в пищеварительный тракт человека могут попадать личинки многоножек. В редких случаях они выживают в агрессивной среде желудка и проникают в кишечник, где из них развиваются половозрелые взрослые формы. Кишечная инвазия многоножек проявляется:
- сильной болью в области живота;
- нарушениями стула;
- кишечными кровотечениями.
 При поражении арахноэнтомозом кишечника возникает сильная боль в животе и нарушения стула
При поражении арахноэнтомозом кишечника возникает сильная боль в животе и нарушения стулаСимптомы заболевания проходят вскоре после выхода паразита наружу.
Арахнозы и акариазы
Арахнозы – разновидность арахноэнтомозов, вызываемых укусами скорпионов и ядовитых пауков. Эти членистоногие при укусе впрыскивают в тело человека яд, способный вызвать сильную интоксикацию.
Лечение арахнозов, причиненных укусами скорпионов или ядовитых пауков, должно начинаться с иммобилизации конечности и наложения жгута выше места укуса.
Место укуса у больного начинает нестерпимо болеть. Быстро развивается локальный отек, мягкие ткани становятся напряженными. По мере всасывания яда возникают и системные проявления интоксикации:
- боль во всем теле;
- слезотечение;
- потливость;
- повышение температуры тела;
- рези в животе;
- судорожные припадки;
- нарушения дыхания.
При укусе ядовитых пауков и скорпионов больные нуждаются в оказании срочной медицинской помощи, так как может развиться острая дыхательная недостаточность, вплоть до летального исхода.
 Арахноз: место укуса ядовитого паука или скорпиона
Арахноз: место укуса ядовитого паука или скорпионаАкариазы – заболевания, вызываемые паразитическими клещами. Данная группа включает в себя свыше 20 заболеваний. У человека наиболее часто встречаются чесотка и демодекоз. Многие виды клещей, обитающих в пыли, не являются патогенными, однако при попадании в дыхательные пути они способны становиться причиной аллергизации чувствительных людей и развития у них бронхиальной астмы.
Источник заражения человека арахноэнтомозами – внешняя среда. Несоблюдение мер личной гигиены является предрасполагающим фактором к развитию заболеваний данной группы у людей.
Основные симптомы чесотки – сильный зуд, усиливающийся в ночное время, и хорошо заметные на коже следы от расчесов. При первичном заражении зуд при чесотке возникает спустя 7-10 дней от момента заражения. При повторных случаях заболевания зуд кожи отмечается уже спустя несколько часов. Это связано с тем, что он вызывается не механическим повреждением кожи клещами, а аллергической реакцией на их экскременты.
 Акариазы: группа заболеваний, вызванных паразитическими клещами
Акариазы: группа заболеваний, вызванных паразитическими клещамиЗаподозрить демодекоз можно на основании следующих симптомов:
- отек глаз;
- гиперемия век;
- отек края век;
- чешуйки возле корней ресниц;
- выпадение ресниц;
- постоянно рецидивирующие ячмени;
- розацеа.
Энтомозы
Самая большая группа арахноэнтомозов, возбудителями которых являются насекомые. Наиболее часто возникающие у людей заболевания данной группы:
- педикулез;
- комариная аллергия;
- гусеничный дерматит;
- аллергия на укусы жалящих насекомых;
- аллергия на тараканов;
- флеботодермия.
Аллергия на укусы насекомых проявляется покраснением кожи в месте поражения, ее отечностью и выраженным зудом.
Опасны укусы жалящих насекомых. В месте ужаления образуется депо токсина, откуда он поступает в организм с током лимфы и крови, иногда вызывая поражение сердечно-сосудистой и дыхательной систем. Подобные укусы сопровождаются развитием аллергических реакций от местных до тяжелых системных (анафилактического шока, отека Квинке).
Флеботодермия (москитный дерматоз) – это заболевание кожи, вызываемое укусами москитов и распространенное в жарких странах (встречается в южных регионах России и республиках Средней Азии). Для него характерно появление на коже папул красноватого цвета, которые в дальнейшем трансформируются в высыпания, напоминающие узловую почесуху.
 Флеботодермия или москитный дерматоз
Флеботодермия или москитный дерматозМоскиты – переносчики многих видов инфекционных заболеваний (в частности, опасных: чумы, брюшного тифа, туляремии).
Читайте также:12 популярных мифов о гельминтозах
Диагностика
Диагностика поверхностных арахноэнтомозов, таких как комариная аллергия, педикулез, чесотка, демодекоз, обычно не вызывает затруднений. В случае глубоких форм заболевания могут возникать диагностические сложности.
Арахноэнтомозы широко распространены среди животных, люди страдают ими значительно реже.
Лечение
Выбор схемы терапии определяется, прежде всего, видом возбудителя.
При мириаподиазах многоножек из полости рта или носа удаляют при помощи пинцета. Из придаточных пазух носа их извлекают путем промывания. При кишечной форме заболевания пациентам назначают солевые слабительные. Для купирования болевого синдрома показано применение нестероидных противовоспалительных препаратов.
Лечение арахнозов, причиненных укусами скорпионов или ядовитых пауков, должно начинаться с иммобилизации конечности и наложения жгута выше места укуса. Пострадавшему дают обильное питье. При болевой реакции является оправданным применение ненаркотических (а при интенсивной боли – и наркотических) анальгетиков. В стационаре больному вводят специфическую противоядную сыворотку, при необходимости – сердечно-сосудистые средства.
Терапия акариазов осуществляется по такой схеме:
- Уничтожение паразитов.
- Ликвидация проявлений дерматоза.
- Обследование на передаваемые клещами инфекции.
Обязательным этапом лечения арахноэнтомозов является исследование паразитов на инфекции
Обязательным этапом лечения арахноэнтомозов является исследование паразитов на инфекцииЛечение энтомозов зависит от вида возбудителя заболевания, органа мишени и интенсивности инвазии.
Возможные осложнения и последствия
Наиболее частые осложнения арахноэнтомозов – гнойно-воспалительные заболевания кожи и системные аллергические реакции.
Профилактика
В целях профилактики арахноэнтомозов необходимо соблюдать ряд правил:
- не спать на земле или траве;
- тщательно осматривать овощи и фрукты перед употреблением;
- проявлять осторожность в местах обитания ядовитых пауков и скорпионов;
- при выездах на природу защищать открытые участки кожи при помощи репеллентов;
- проводить активное уничтожение паразитов при помощи дезинсекции, деларвации.
Об авторе

Опыт работы: врач анестезиолог-реаниматолог городского родильного комплекса, врач реаниматолог отделения гемодиализа.
Информация является обобщенной и предоставляется в ознакомительных целях. При первых признаках болезни обратитесь к врачу. Самолечение опасно для здоровья!
Желудок человека неплохо справляется с посторонними предметами и без врачебного вмешательства. Известно, что желудочный сок способен растворять даже монеты.
























